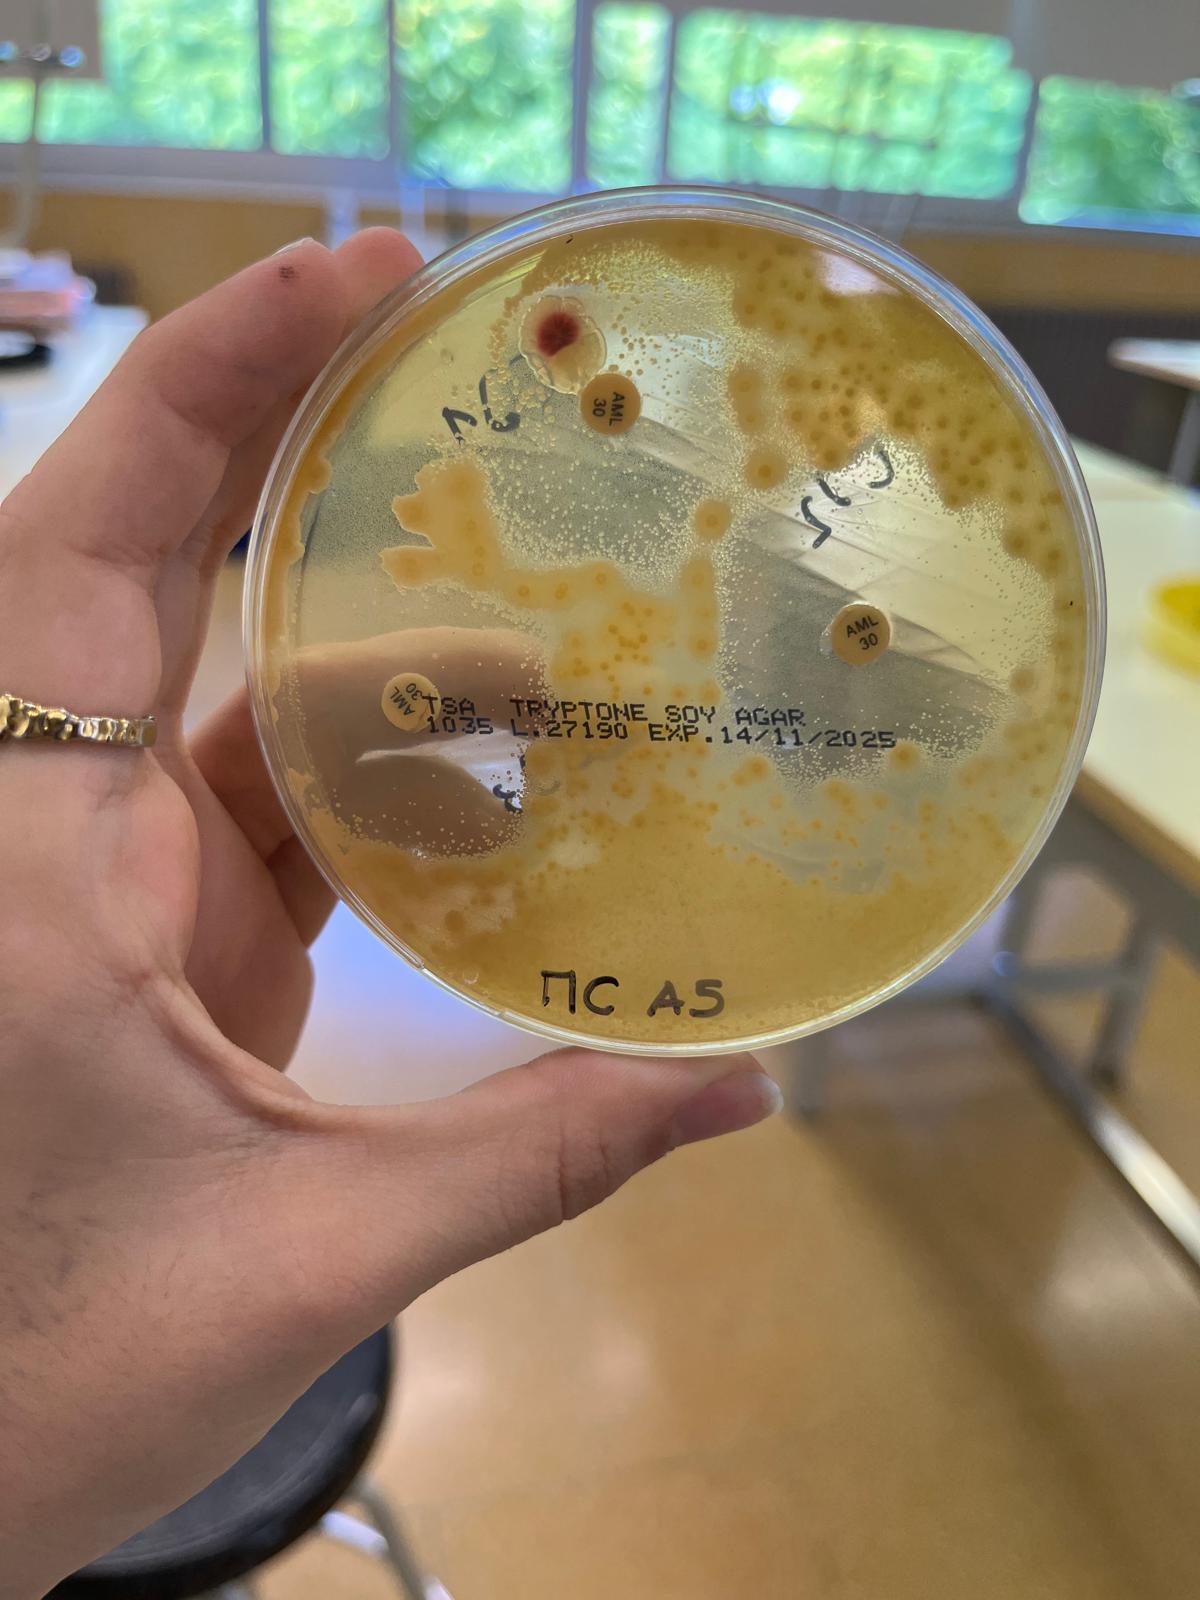
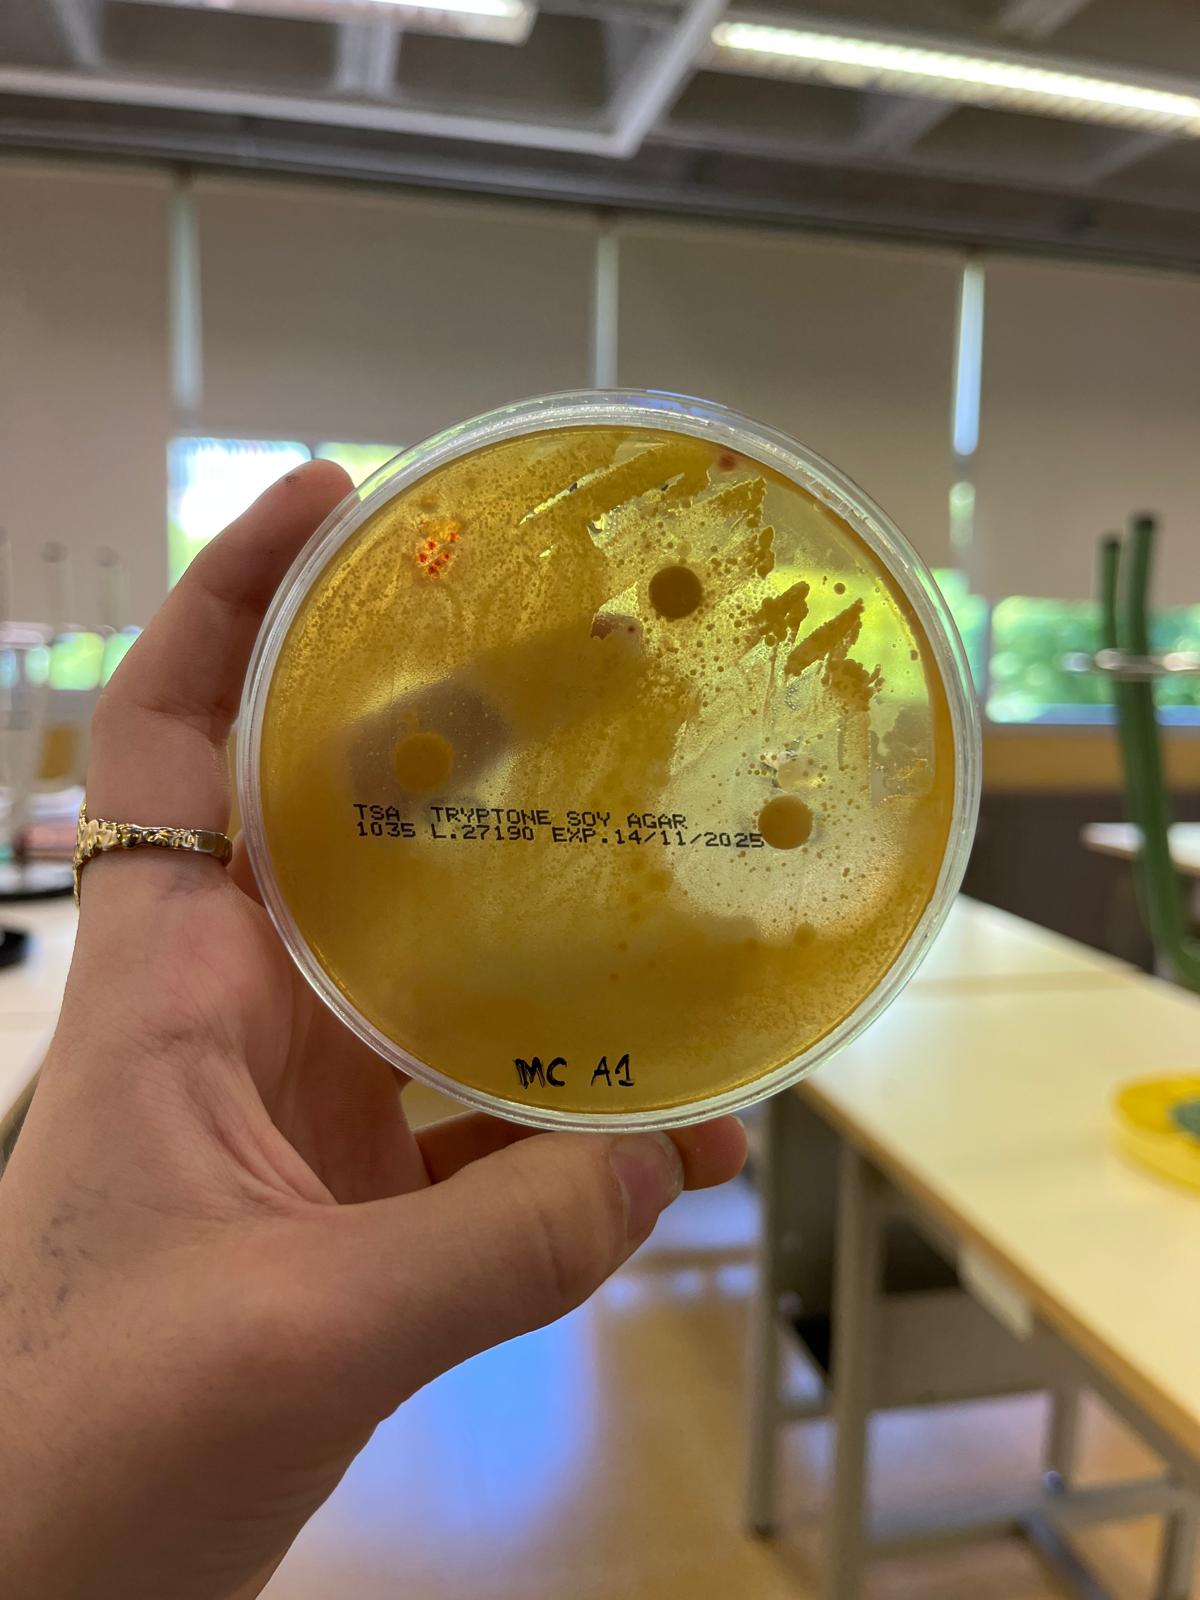

El treball de recerca és una tasca d’investigació que fa tot alumnat de batxillerat. Es treballa aproximadament des de finals de 1r de batxillerat i durant el primer trimestre de 2n de batxillerat.
Des de l’Institut Pere Ribot volem reconèixer l’excel·lència i publicar entrevistes a l’alumnat que així ho desitgi que hagi obtingut una nota de 10 i d’aquesta manera reconèixer el gran esforç realitzat.
Continuem aquesta sèrie d’entrevistes amb l’Andrea Castro i la primera cosa que volem fer és felicitar-te per la nota, però sobretot per l’esforç i la implicació que has tingut en la seva confecció, és a dir, per la feina feta.
El teu treball es titula Comparació de l’efectivitat d’antibiòtics sintètics i d’antibiòtics naturals sobre cultius bacterians i de ben segur que podries estar hores parlant d’ell, però hem d’intentar sintetitzar. És per això que ens deixarem coses de les quals parlar i, per tant, ja demanem disculpes per endavant.
Però, anem al gra!
El primer de tot és saber perquè has escollit aquest tema. Què et va portar a decidir-te, quina va ser la teva motivació?
Tenia clar que el meu treball havia de ser de biologia i de la medicina perquè la meva intenció era estudiar a la universitat aquest àmbit de la ciència.
Em vaig preguntar si algun remei tradicional fet a casa tenia propietats antibacterianes i que pogués ser efectiu contra bacteris de la mateixa manera que els antibiòtics sintètics. I aquesta va ser la base i el punt de partida del meu treball de recerca.
Ara et demanaré una cosa molt difícil: resumeix-nos en un parell de frases tot el teu treball.
En el meu treball de recerca comparo l’eficàcia dels antibiòtics naturals i els sintètics davant determinats patògens.
Tot i que el resultat del treball és evidentment excel·lent, de ben segur que has tingut moments de dubtes, de densa documentació, … Has trobat gaires entrebancs o dificultats per confeccionar el teu treball?
El meu treball es basa en una tasca bàsicament experimental de laboratori, i ho he fet al laboratori de l’institut, que té les seves mancances i limitacions en temes d’esterilitat. Tot i això no ha limitat el meu treball, només l’ha dificultat.
De tot el treball i del seu procés de confecció, quin és el coneixement, la dada o la conclusió que més t’ha impactat i que t’agradaria destacar?
El fet de veure de primera mà les inhibicions dels radis dels antibiòtics ha estat molt interessant.
Del teu treball, vols destacar algun altre aspecte o explicar alguna anècdota?
Les plaques de farigola i de gingebre no van tenir cap inhibició en cap bacteri però si que van aparèixer fongs que per manca de temps i de recursos no vaig poder analitzar.
Quan parles dels antibiòtics no m’ha quedat clar si aquests maten el bacteri o simplement inhibeixen el seu creixement.
De fet hi ha dos tipus de bacteris, els bactericides, que són els que maten el bacteris i els bacteriostàtics, que frenen el creixement i ajuden al sistema immunitari a poder superar la infecció.
Quan dius que fas els antibiogrames parles que sembres bacteris. D’on has tret els bacteris?
Els bacteris me’ls ha facilitat l’institut, a través del CESIRE que és el Centre de Recursos Pedagògics Específics de Suport a la Innovació i a la Recerca Educativa del Departament d’Educació.
Et fan arribar els bacteris en unes dissolucions i amb una pipeta els vaig sembrar a les plaques de petri.
Parles de bacteris capaços de viure en medis extrems.
Sí, per exemple el serratia marcescens que a l’experiment ha estat resistent a tots els antibiòtics excepte a l’amoxicil·lina, és capaç de viure a gairebé tots els medis possibles que hi ha a la terra i això els permet tenir una resistència molt alta.
Tots els antibiòtics serveixen per a tots els bacteris?
No. Hi ha antibiòtics que ataquen a la paret cel·lular del bacteri, n’hi ha que inhibeixen, i segons el bacteri que tinguis serà més efectiu un o un altre antibiòtic. Tot i així hi ha antibiòtics d’espectre ampli com per exemple l’amoxicil·lina.
Quan de temps has de deixar actuar els antibiòtics amb els bacteris a les plaques de petri per poder obtenir resultats fiables? I en quines condicions?
Vaig haver de posar aquestes plaques a la incubadora de l’institut, a una certa temperatura durant uns tres dies per fer les primeres observacions, després dos dies més. Es tracta de fer un seguiment constant.
Vols afegir alguna cosa més abans d’acabar l’entrevista?
Abans d’acabar m’agradaria destacar que dels antibiòtics naturals només l’all ha aconseguit efectes antibacterians. La farigola i el gingebre no van tenir cap inhibició i per tant puc concloure que no son antibacterians però sí antiinflamatoris.
Doncs acabem aquí aquesta entrevista tan interesant, i és obligat un agraïment a l’Andrea per la seva col·laboració i un reconeixement a la professora Elisa Vegas, que ha tutoritzat aquest treball.